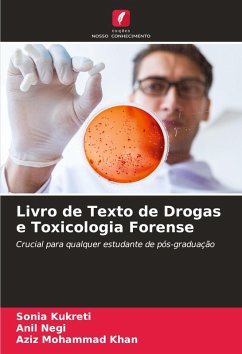

Este livro tem como objetivo ensinar os fundamentos da toxicologia e dos produtos farmacêuticos forenses aos estudantes de medicina indianos. Trata-se de um extenso trabalho de amor que procura apresentar a matéria da forma mais metódica e estruturada que se possa imaginar. O objetivo é explorar até ao último pormenor os sinais de toxicodependência e de poluentes. Todas as rubricas do capítulo básico de Medicina Legal e Toxicologia estão claramente divididas em subtópicos e subtítulos.
Bitte wählen Sie Ihr Anliegen aus.
Rechnungen
Retourenschein anfordern
Bestellstatus
Storno